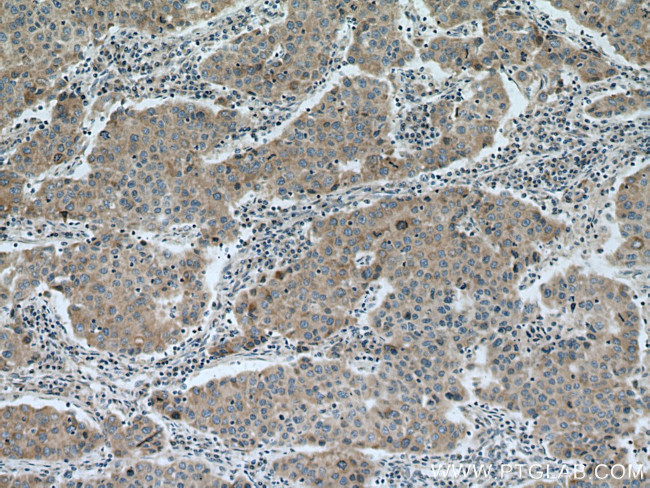
TIMM17A Antibody in Immunohistochemistry (Paraffin) (IHC (P))

Search
Proteintech
TIMM17A Polyclonal Antibody
{{$productOrderCtrl.translations['antibody.pdp.commerceCard.promotion.promotions']}}
{{$productOrderCtrl.translations['antibody.pdp.commerceCard.promotion.viewpromo']}}
{{$productOrderCtrl.translations['antibody.pdp.commerceCard.promotion.promocode']}}: {{promo.promoCode}} {{promo.promoTitle}} {{promo.promoDescription}}. {{$productOrderCtrl.translations['antibody.pdp.commerceCard.promotion.learnmore']}}
产品信息
11189-1-AP
种属反应
已发表种属
宿主/亚型
分类
类型
抗原
偶联物
形式
浓度
规格
纯化类型
保存液
内含物
保存条件
运输条件
产品详细信息
Immunogen sequence: MEEYAREPC PWRIVDDCGG AFTMGTIGGG IFQAIKGFRN SPVGVNHRLR GSLTAIKTRA PQLGGSFAVW GGLFSMIDCS MVQVRGKEDP WNSITSGALT GAILAARNGP VAMVGSAAMG GILLALIEGA GILLTRFASA QFPNGPQFAE DPSQLPSTQL PSSPFGDYRQ YQ (1-171 aa encoded by BC015098)
靶标信息
Translocation of nuclear encoded preproteins into the mitochondrial matrix requires the coordinated action of the translocases Tom and Tim, which are located in the outer mitochondrial membrane and the inner membrane, respectively. The mitochondrial preprotein translocases of the outer membrane (Tom) is a multi-subunit protein that contains at least eight proteins: four import receptor subunits (Tom70, Tom37, Tom22, and Tom20), three small proteins (Tom7, Tom6, and Tom5), and a structural component of the outer membrane channel (Tom40). The Tom machinery involves the import receptors, which initiate the binding of cytosolically synthesized preproteins to the outer membrane, and a general import pore (GIP), which promotes the translocation of various pre-proteins into the mitochondria. The TIM channel imports nuclear-encoded mitochondrial preproteins, and it involves three proteins, Tim17, Tim23 and Tim44, which are represented at equimolar ratios. Tim17 is expressed as two isoforms Tim17a and Tim17b, which differ only in their C termini sequences, and like Tim23, these proteins are ubiquitously expressed in fetal and adult tissues. Tim17 and Tim23 are integral membrane proteins that comprise the structural elements of the inner membrane channel by which the preproteins are transferred. The Tim44, on the other hand, is a largely hydrophilic protein that recruits the matrix located Hsp70 to the site where the preprotein emerges from the Tim channel.
仅用于科研。不用于诊断过程。未经明确授权不得转售。
生物信息学
蛋白别名: Inner membrane preprotein translocase Tim17a; Mitochondrial import inner membrane translocase subunit Tim17-A; mitochondrial inner membrane translocase; preprotein translocase; translocase of inner mitochondrial membrane 17 homolog A; translocase of inner mitochondrial membrane 17a; translocator of inner mitochondrial membrane 17 kDa, a; translocator of inner mitochondrial membrane 17a; translocator of inner mitochondrial membrane a; unnamed protein product
基因别名: 17kDa; MIMT17; mTim17a; TIM17; TIM17A; TIMM17; TIMM17A
UniProt ID: (Human) Q99595, (Mouse) Q9Z0V8, (Rat) O35092
Entrez Gene ID: (Human) 10440, (Mouse) 21854, (Rat) 54311